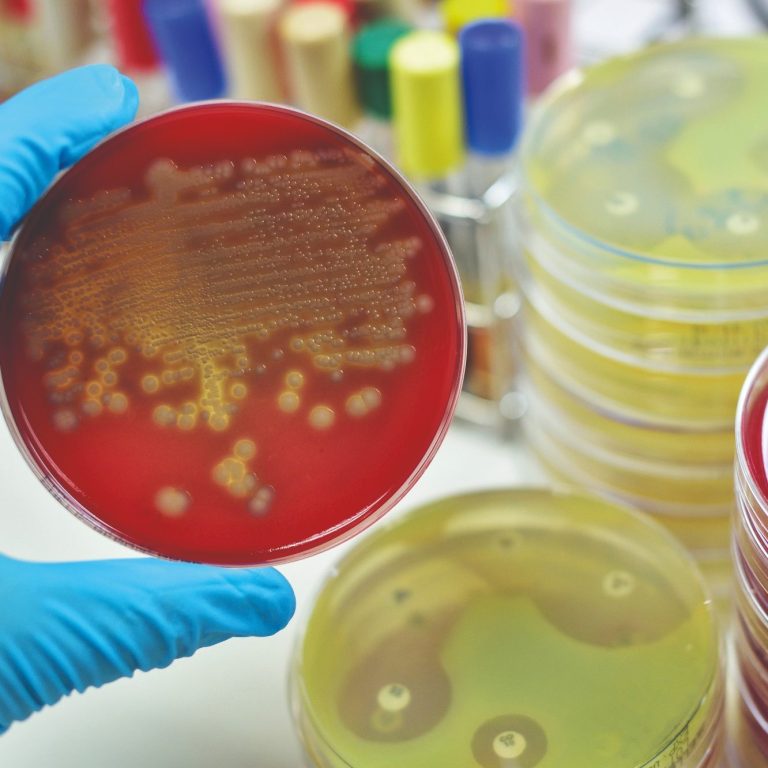

OBJETIVOS
- Proporcionar a los participantes una formación sólida y actualizada sobre la relación entre la microbiota intestinal y cutánea, y su impacto en la salud dermatológica, con el fin de aplicar este conocimiento en la prevención, diagnóstico y tratamiento integral de las enfermedades de la piel.
- Desarrollar en los dermatólogos una comprensión profunda y aplicada del papel del microbioma humano —especialmente el intestinal y cutáneo— en la fisiopatología, diagnóstico y tratamiento de enfermedades dermatológicas, integrando evidencia científica actual y terapias moduladoras como probióticos y simbióticos.
PROFESORADO EXPERTO
Docentes e investigadores de reconocido prestigio mundial, que aunan + de 2.000 artículos, muchos de ellos referentes mundiales en microbiota y estudios del eje enterocutáneo
+25 TEMAS DOCENTES
Impartidos por expertos en estudios de microbiota cutánea e intestinal, maduración inmune y disbiosis y aplicaciones clínicas en dermatólogia.
SIMPOSIO Y PRÁCTICAS
Con simposios internacionales, charlas magistrales y posibilidad de realizar prácticas, en centros referentes,como plus añadido al temario del curso.
Avance del Curso
Estos son algunos de los temas a abordar en los distintos módulos del curso. Accede al temario completo realizando la
preinscripción y no pierdas esta oportunidad.
Plazas Limitadas.

Fundamentos de la Microbiota
Estructura académica.
- Conceptos básicos sobre la microbiota y su composición.
- Métodos de estudio y técnicas de análisis.
- Maduración inmune y su relación con la microbiota. Procesos de disbiosis.
- Aspectos metodológicos comunes para el estudio de la microbiota.
- Fundamentos aplicables a diversas patologías relacionadas con el desequilibrio microbiano.

Microbiota en Patologías Cutáneas
- Acné.
- Rosácea.
- Dermatitis atópica.
- Alopecia areata.
- Psoriasis.
- Hidrosadenitis supurativa.
- Envejecimiento celular y otras patologías inflamatorias

Probióticos e Intervenciones Clínicas
- Acné
- Rosácea
- Dermatitis atópica
- Psoriasis
- Alopecia areata
- Miscelanea de otras patologías con alguna prueba de concepto.
Microbiota, Biomarcadores y Perspectivas Futuras
- La microbiota como biomarcador diagnóstico y pronóstico.
- Caracterización de la microbiota cutánea, intestinal y salivar.
- Biofilms y su relación con la microbiota.
- Aplicaciones de la inteligencia artificial en el estudio de la microbiota.
- Futuro de la investigación en microbiota y su impacto en las dermopatías.


